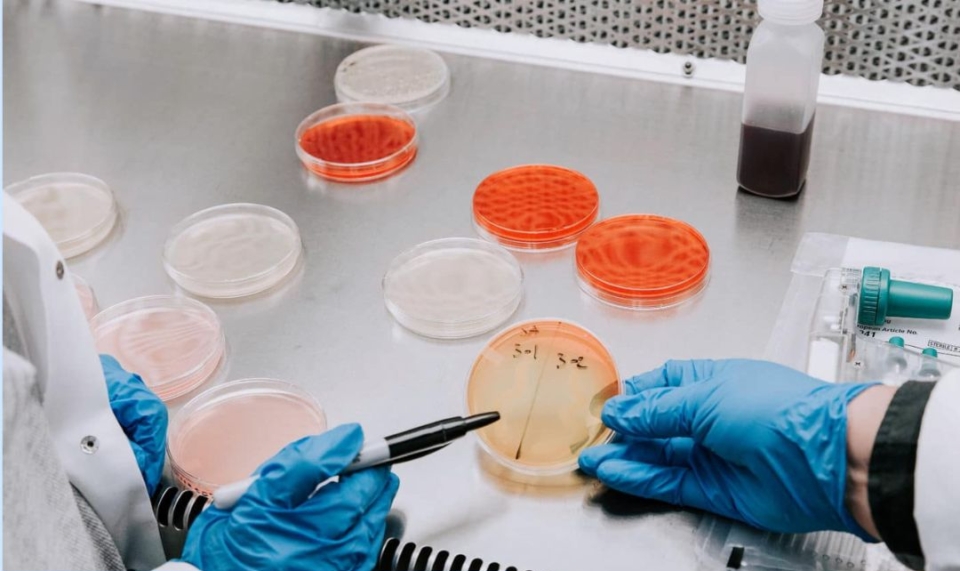

Інформуємо Вас, що за даними моніторингу захворюваність на гострі кишкові інфекції за звітний тиждень, порівняно з попереднім, знизилась на 24%, у тому числі серед дитячого населення – на 24,6%, серед дорослого – на 23%. Основна питома вага серед захворілих припадала на дітей (до 56%) і найбільш ураженими серед них була вікова група 1-4 роки (42%).
Згідно з факторним аналізом переважна більшість хворих пов’язували своє захворювання з вживанням немитих ягід, фруктів та баштанних культур, а також готових домашніх страв з порушенням технології приготування та зберігання (по 30%); 12% – з вживанням м’ясних та молочних продуктів, придбаних на ринках у приватних осіб; 6% – з недотриманням особистої гігієни та правил догляду за дітьми, у т.ч. у зонах рекреації; по 5% – з вживанням яєць та молочних сумішей з порушенням термінів та умов зберігання; 4% – з купанням в морі; по 2% – морепродуктів та кондитерських виробів. У 5% випадків фактор захворювання не встановлений.
За звітний тиждень, з метою моніторингу циркуляції холерного вібріону на об’єктах довкілля (вода відкритих водоймищ, морська вода в зонах рекреації, стічна вода інфекційних стаціонарів/відділень та очисних споруд), було досліджено 89 проб, у тому числі морської води – 24, прісної – 22, стічної – 38 (з них з інфекційних відділень – 17), баластної – 5.
За результатами досліджень холерний вібріон не виділено. Випадки підозри на вірусний гепатит А за звітний тиждень не реєструвались. З початку року зареєстровано 3 лабораторно підтверджених випадки серед дорослих.
Захворюваність на гострі респіраторні вірусні інфекції (ГРВІ) знаходилась на сезонному рівні і була нижче епідемічного порогу на 61,8% (203,0 проти 532,0), що відповідає низькому рівню інтенсивності епідпроцесу.
За останній тиждень спостерігалось незначне зростання захворюваності на 27 випадків за рахунок дорослого населення, де ріст на 6,6%. Проте серед дітей до 17 років відмічалось зниження на 5%. Серед захворілих превалювали дорослі (до 51%), найбільш ураженою була вікова група 30-64 роки – 60%.
До стаціонарів госпіталізовано 297 хворих, що на 6% більше ніж на попередньому тижні. Серед госпіталізованих переважали діти (68%).
У загальній сумі захворілих на ГРВІ збільшилась питома вага COVID-19 і складала 14,5% проти 9,1% на попередньому тижні. Зареєстровано 689 випадків (проти 432) – зростання на 60%. Серед захворілих на COVID-19 також переважало доросле населення (76%) з превалюванням вікової групи 30-64 роки (61%). Показник госпіталізації хворих на COVID-19 зріс на 42%.
Летальних випадків не зареєстровано.
За даними моніторингу вірусологічних досліджень біоматеріалу від хворих серед населення циркулюють лише віруси COVID-19.
Повітряно-крапельні інфекції, які керуються засобами специфічної профілактики, реєструвались спорадичними випадками (кашлюк, епідпаротит) або не реєструвались зовсім (кір, краснуха, дифтерія, правець).
З початку року в області зареєстровано 49 підтверджених випадків кору, з них 31 дитина (63,3%) та 1 летальний випадок від ускладнення кору дитини (9 міс.).
Із 49 хворих не щеплено 33 (67,3%), отримали 1 дозу – 7 осіб (14,3%), 2 дози – 9 (18,4%).
Ареал розповсюдження кору – 5 адміністративних територій (14 громад): Ізмаїльський район (24 випадки), Одеський (18), Болградський (3), Б.Дністровський (2) та Березівський (2).
Із групи особливо небезпечних інфекцій на звітному тижні зареєстровано 3 випадки підозри на хворобу Лайма в Одеському (2) та Подільському (1) районах.
За даними моніторингу за звітний період отримали укуси тваринами 112 осіб проти 82 на попередньому тижні.
З початку року в області лабораторно підтверджено 217 випадків сказу серед тварин, з них 208 – серед диких (лисиці, шакали) та 9 – серед свійських (коти, собаки). Випадки реєструвались на всіх адміністративних територіях: Подільський район – 57, Березівський – 47, Болградський – 33, Ізмаїльський – 31, Б-Дністровський – 28, Роздільнянський – 20 та Одеський – 1.
Епідемічна ситуація залишається на контролі.